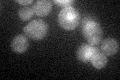
YDR003W
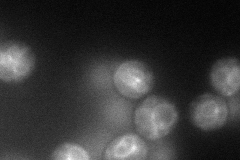
YDR003W
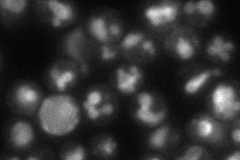
YDR003W
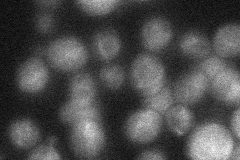
YDR003W
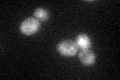
YDR003W
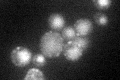
YDR003W

View description
Vacuolar protein that presumably functions within the endosomal-vacuolar trafficking pathway, affecting events that determine whether plasma membrane proteins are degraded or routed to the plasma membrane; similar to Rcr1p
Localization:
Intensity:
Fold change:
Significance:
-
C’ GFP library in SD
vacuole:cytosol28.53 -
N' NOP1pr-GFP in SD
vacuole membrane67.9252 -
N' TEF2pr-mCherry in SD
vacuole membrane64.256 -
N' NATIVEpr-GFP in SD
ambiguous25.3668 -
N' TEF2pr-VC and Cyto-VN in SD

below threshold24.3858 -
C’ GFP library in SD+DTT
vacuole.cytosol31.11.08No -
C’ GFP library in SD+H2O2

vacuole.cytosol24.180.84No -
C’ GFP library in Starvation Media
vacuole,cytosol66.212.32Yes -
C’ GFP library on the background of Pup2-DaMP

vacuole:cytosol -
C’ GFP library on the background of CCT mutant

vacuole:cytosol30.42811.06626No
